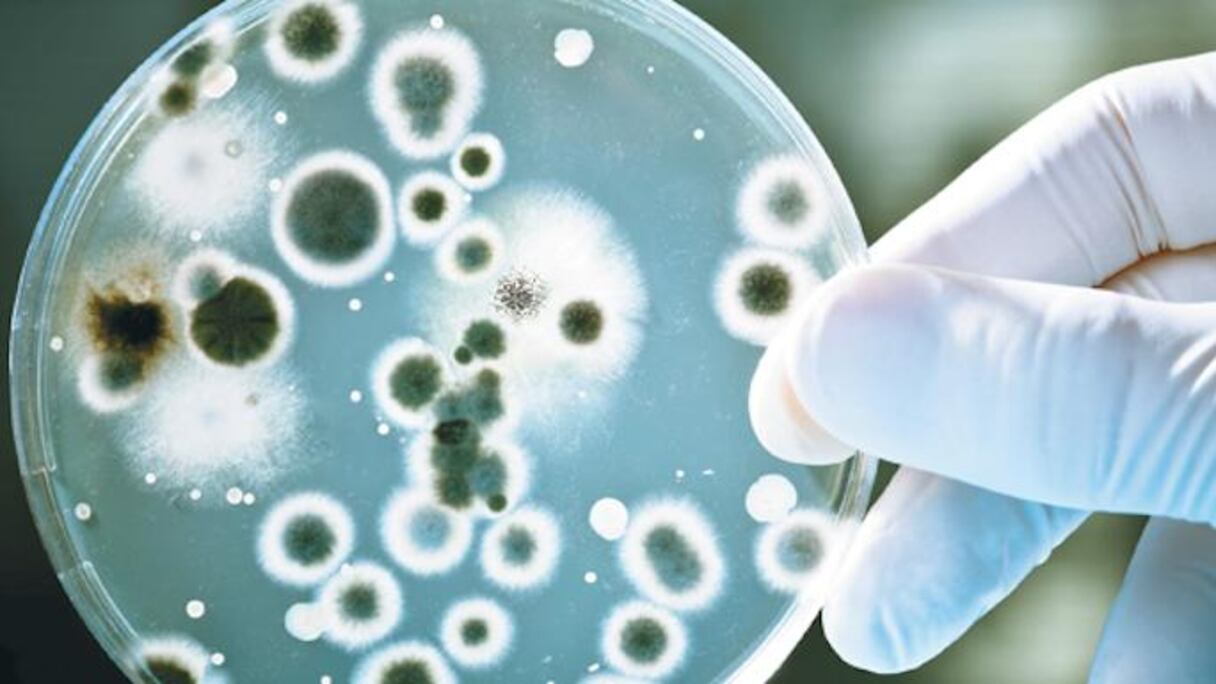

Depuis janvier 2017, 915 cas ont été confirmés. Parmi eux, 172 personnes sont décédées de cette maladie infectieuse, qui se transmet le plus souvent à l'homme par l'intermédiaire d'aliments contaminés.
Il s'agit de la pire épidémie de listériose jamais enregistrée dans le monde, selon les Nations unies.
"La source de l'épidémie n'a pas encore été déterminée", a déploré le gouvernement sud-africain dans un communiqué, précisant que la plupart des cas ont été enregistrés dans la région de Johannesburg et Pretoria.
Lire aussi : Zika: découverte d'anticorps capables de «neutraliser» le virus
Les autorités sud-africaines ont appelé la population à respecter des règles d'hygiène (lavage régulier des mains, cuisson à forte température des aliments...), tout en l'exhortant à "ne pas paniquer inutilement".
La listériose figure parmi les zoonoses - maladies transmises de l'animal à l'homme - les plus dangereuses. Elle provoque généralement de la fièvre, des vomissements et des diarrhées et se traite par antibiotiques.
Les sujets sensibles, comme les personnes âgées, les nouveaux-nés, les femmes enceintes ou les patients au système immunitaire affaibli, sont plus exposés aux complications, notamment méningites et septicémies.